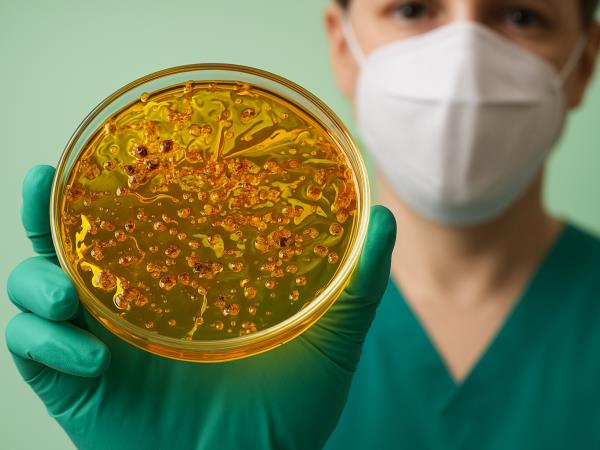
Domače zdravilo proti MRSA, ki je osupnilo zdravnike

Datum: 16.6.2023 - Rubrika:
Zanimivosti
Naravna sestavina, ki so jo pri MRSA preizkušali tudi v kliničnih študijah
Avtor:
uredništvo Vem, kaj jem
Med raziskovanjem je skupina britanskih zdravnikov naletela na preprosto zdravilo iz 9. stoletja - izkazalo se je, da gre za zdravilo proti bolnišnični bakteriji
Članek je bil ustvarjen leta 2023, letos smo že preverili nekatera dejstva, preostali del pa bomo kmalu še dopolnili in nadgradili. Trudimo se, da bi bili članki na Vem, kaj jem ažurirani z najnovejšimi dognanji. Sodobna znanost namreč skoraj vsak dan odkrije kaj novega ...
Ali so zdravilci pred tisoč leti poznali MRSA? Je MRSA res sodobna bolnišnična bolezen? Je redno jemanje tega domačega zdravila res najboljše zdravilo proti MRSA doslej?
MRSA je okužba pridobljena v bolnišnici ali ob kakih drugih zdravstvenih posegih. Običajno pride do hudih pljučnic, okužb sečil, otečenost ... MRSA je težko zdraviti, ker so bakterije odporne proti antibiotikom, problem te bolezni pa je, ker ogrožajo tudi ljudi zunaj bolnišnic.
Vendar pozor!
Nedavno odkritje iz 9. stoletja opisuje metodo zdravljenja bolezni, ki ji danes pravimo MRSA. Takratni zdravilci so pripravili kombinacijo kravjega želodca, česna in čebule. Bolnik mora med 10-dnevnim zdravljenjem jesti vsak dan vsaj 100 gramov te nenavadne mešanice, pomaga pa si lahko z rdečim vinom, ki pa mora biti v razmerju 1 : 1.
Znanstvenike je najbolj presenetilo prav dejstvo, da je tak način zdravljenja učinkovit tudi danes. Testiranja so pokazala, da lahko na tak način pozdravimo 90 % obolenj.
MRSA je okužba pridobljena v bolnišnici ali ob kakih drugih zdravstvenih posegih. Običajno pride do hudih pljučnic, okužb sečil, otečenost ... MRSA je težko zdraviti, ker so bakterije odporne proti antibiotikom, problem te bolezni pa je, ker ogrožajo tudi ljudi zunaj bolnišnic.
Vendar pozor!
Nedavno odkritje iz 9. stoletja opisuje metodo zdravljenja bolezni, ki ji danes pravimo MRSA. Takratni zdravilci so pripravili kombinacijo kravjega želodca, česna in čebule. Bolnik mora med 10-dnevnim zdravljenjem jesti vsak dan vsaj 100 gramov te nenavadne mešanice, pomaga pa si lahko z rdečim vinom, ki pa mora biti v razmerju 1 : 1.
Znanstvenike je najbolj presenetilo prav dejstvo, da je tak način zdravljenja učinkovit tudi danes. Testiranja so pokazala, da lahko na tak način pozdravimo 90 % obolenj.
Vsebina je informativne narave in ne nadomešča nasveta zdravnika. Pri pripravi so bili uporabljeni javno dostopni strokovni viri, priporočila WHO, EFSA in drugih organizacij.
vkj
O AVTORJU:
Članek je uredniško pregledal Zvone Štor, ki sicer nima formalne nutricionistične izobrazbe, a že vrsto let pa spremlja tende na področju zdrave hrane in zdravega načina življenja. Članek ni zdravniški nasvet.
Članek je uredniško pregledal Zvone Štor, ki sicer nima formalne nutricionistične izobrazbe, a že vrsto let pa spremlja tende na področju zdrave hrane in zdravega načina življenja. Članek ni zdravniški nasvet.
MRSA

* Na ta naslov vam bomo pošiljali samo e-bilten enkrat na teden. Odjavite se lahko kadarkoli.

Zdravje, lepota
Napitek iz jagod in chia semen za razstrupljanje
Napitek z veliko vitamini, antioksidanti, z izjemnim razstrupljevalnim učinkom, ki bo premagal tudi najhujšo lakoto.
VEČ >

Zanimivosti
Naravna sestavina, ki so jo pri MRSA preizkušali tudi v kliničnih študijah
VEČ >

Zdravje, lepota
Najbolj zdravo sadje v juniju
VEČ >

Dobro je vedeti
5 naravnih odganjalcev komarjev za mirnejši dom
VEČ >

Dobro je vedeti
Spanje proti debelosti in sladkorni bolezni
VEČ >

Dobro je vedeti
7 stvari, ki jih nikoli ne smete početi po obroku
Po obroku si pogosto privoščimo nekaj, kar se nam zdi sproščujoče ali koristno: cigareta, sadje, čaj, sprehod ali celo kratek počitek ... Pozor s tem!
VEČ >

Dobro je vedeti
Ali pivo vsebuje gluten?
VEČ >

Dobro je vedeti
Če imate te težave, se izogibajte jagodam
VEČ >

Dobro je vedeti
3 živila, ki se lepijo na želodec
VEČ >

Dobro je vedeti
4 razlogi, zakaj morate takoj nehati uporabljati plastične posode
VEČ >
Naložite mobilno aplikacijo:

Poslikajte hrano in spremljate kalorije, beljakovine, vlaknine, ogljikove hidrate in maščobe. Naj bo vaša prehrana bolj uravnotežena ...
Več o aplikaciji najdete TUKAJ





















